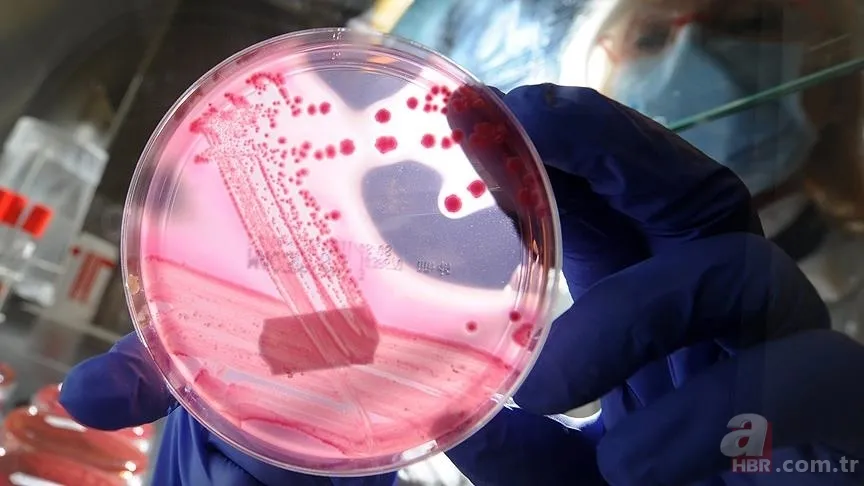
SMA hastalığı nedir, neden olur? Tedavisi var mı, belirtileri neler? SMA hangi yaşlarda kimlerde görülür? 3

SMA hastalığı nedir, neden olur? Tedavisi var mı, belirtileri neler? SMA hangi yaşlarda kimlerde görülür?
SMA hastalığı nedir, neden olur sorusunun cevabı sıklıkla merak ediliyor. Son günlerde adını sıklıkla duyduğumuz SMA hastalığının ne olduğu ve neden kaynaklandığı öğrenilmeye çalışılıyor. Peki SMA hastalığı nedir, neden olur? SMA tedavisi var mı, belirtileri neler? SMA hangi yaşlarda kimlerde görülür?

Didem Gülmez olayının ardından SMA hastalığı ile ilgili detaylar merak edilmeye başlandı. SMA hastası Mustafa Yağız Gülmez hayata gözlerini kaparken, anne Didem Gülmez'in çocuğu için toplanan paraları evli bir adamla yediği ortaya çıktı. Tüm Türkiye'nin konuştuğu bu olayın ardından vatandaşlar SMA hastalığının ne olduğunu ve neden kaynaklandığını araştırmaya başladı. İşte SMA hastalığı ile ilgili detaylar...

SMA NEDİR?
Spinal müsküler atrofi (SMA), ikinci motor nöronların kalıtımsal bir hastalığıdır. İstemli kaslarda kuvvetsizlik ve erime yapan hastalık, sinir hücrelerinin işlevini yerine getirememesine, zayıflamaya ve genellikle ölümcül kas güçsüzlüğüne yol açıyor.
SMA HASTALIĞI BELİRTİLERİ
Semptomlar SMA tipine, hastalığın evresine ve bireysel faktörlere bağlı olarak değişir. İşte SMA hastalığının belirtileri:
*Özellikle ekstremitelerde arefleksiGenel kas zayıflığı, zayıf kas tonusu, gevşeklik ya da düşme eğilimi
*Gelişimsel kilometre taşlarına ulaşmada zorluk; oturma, ayakta durma, yürüme zorluğu
*Küçük çocuklarda: otururken kurbağa bacağı pozisyonunun benimsenmesi (kalçanın kırılması ve dizlerin bükülmesi)
*Solunum kaslarında güç kaybı: zayıf öksürük, zayıf ağlama (çocuklarda), akciğerlerde veya boğazda salgı birikimi, solunum güçlüğü
*Ağır SMA tiplerinde çan biçimli gövde (solunum için sadece karın kaslarının kullanılmasından kaynaklanır)Dilde fasikülasyonlar (seğirme)
*Emme veya yutma güçlüğü, yetersiz beslenme

SMA HANGİ YAŞLARDA KİMLERDE GÖRÜLÜR?
SMA hastalığının dört farklı tipi vardır. Bu sınıflandırma hastalığın başladığı yaşı ve yapabildiği hareketleri temsil eder. 6 aylık ve daha küçük bebeklerde belirtileri görülen tip-1 SMA en ağır seyirli olandır.
Tip-2 SMA ise 6-18 aylık bebeklerde görülür. Bu dönemden önce bebeğin gelişimi normalken bu dönemde belirtiler başlar. Başlarını kontrol edebilen tip-2 hastaları tek başlarına oturabilseler de desteksiz ayakta duramaz ve yürüyemezler. Kendi başlarına doğrulamazlar.

Tip-3 SMA hastalarının belirtileri 18. aydan sonra başlar. Bu döneme kadar gelişimleri normal olan bebeklerin, SMA belirtilerinin fark edilmesi ergenlik dönemini bulabilir.
Kişilerin yetişkinlik döneminde semptomlarını göstermesiyle bilinen tip-4 SMA, diğer tiplere göre daha nadir olarak görülür ve hastalığın ilerleyişi yavaştır. Tip-4 hastaları nadiren yürüme, yutma ve solunum becerilerini yitirir.




